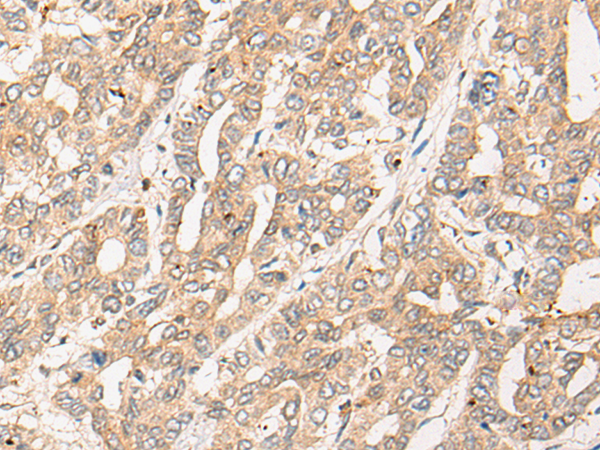

|
Background: |
NADH-cytochrome b5 reductases are involved in desaturation and elongation of fatty acids, cholesterol biosynthesis, drug metabolism, and, in erythrocyte, methemoglobin reduction. |
|
Applications: |
ELISA, IHC |
|
Name of antibody: |
CYB5R4 |
|
Immunogen: |
Fusion protein of human CYB5R4 |
|
Full name: |
cytochrome b5 reductase 4 |
|
Synonyms: |
NCB5OR; cb5/cb5R; dJ676J13.1 |
|
SwissProt: |
Q7L1T6 |
|
ELISA Recommended dilution: |
5000-10000 |
|
IHC positive control: |
Human liver cancer |
|
IHC Recommend dilution: |
25-100 |
購物車
購物車 幫助
幫助
 021-54845833/15800441009
021-54845833/15800441009
